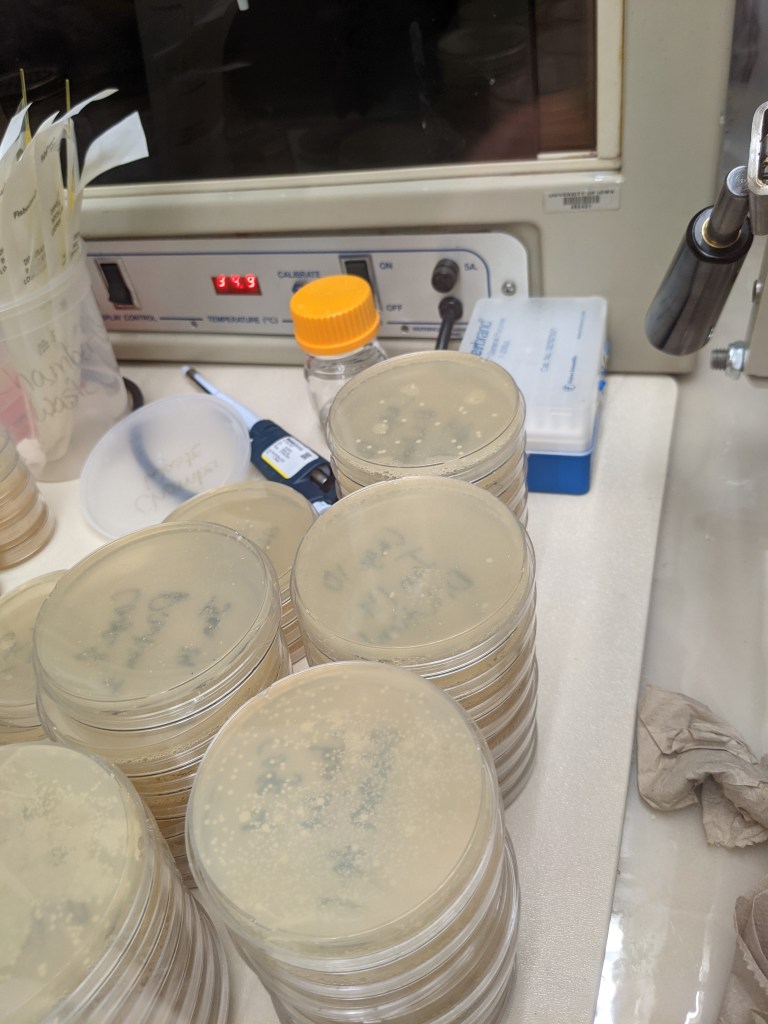
Stacks of petri dishes filled with culture media, some of which have bacterial colonies growing on them.

This has been a busy year for the Ishaq Lab, which has been at UMaine since September of 2019 and has built up significant momentum in that time, despite the ongoing challenges of trying to accomplish research and education during a pandemic.
Team

Graduate and undergraduate students are critical members of the Ishaq Lab, where they assist with or perform their own research, and are both mentored by me or are being cross-trained by me to complement the work they perform in their primary lab. A crowd of students have been in the Ishaq Lab over the course of this year, which wasn’t apparent until I tallied them for research outcomes reporting purposes, as some are partially or entirely remote, and we’ve never all gathered in one place. Partly, because of pandemic safety precautions, and partly, because of busy schedules, the entire research group had not been able to meet in person for most of the last two years, and it was only this year that we finally got a group photo. Of course, that photo was almost immediately inaccurate as we welcomed several new members this fall to add to our collective expertise.
| Students mentored | 09/2019-06/2020 | 07/2020 – 06/2021 | 07/2021-06/2022 |
| Total all | 9 | 28 | 24 |
| PhD, committee member | 1 | 2 | 3 |
| MS, primary mentor | 0 | 2 | 2 |
| MS, committee member | 2 | 3 | 2 |
| MPS, primary mentor | 1 | 1 | 0 |
| Honors, primary mentor | 1 | 2 | 0 |
| Honors, committee member | 0 | 1 | 1 |
| Capstone | 1 | 10 | 12 |
| Top Scholar | 0 | 1 | 1 |
| BS, primary mentor | 2 | 0 | 0 |
| REU | 1 | 1 | 1 |
Despite the challenges of the pandemic and a busy school schedule, the students did phenomenal work. Nick Hershbine who was working on soil bacterial communities was named a 2020-2021 University of Maine Undergraduate Student Employee of the Year, and Johanna Holman who is leading the mouse microbiome diet studies was named a 2020-2021 University of Maine Graduate Student Employee of the Year. Tindall Ouverson who was working on soil bacterial communities in Montana won first prize in the graduate students poster competition at the 2021 Montana State University LRES research colloquium. Rebecca French who is part of the ‘squirrel crew’ was awarded a 2021 research award from the J. Franklin Witter Undergraduate Research Endowment Fund, and several students had their first paper published or first scientific presentation (those are listed below). Sarah Hosler has been managing three research projects, involving over a hundred samples and the training/oversight of seven undergraduate researchers.

My dog, Izzy, started coming to campus this fall to avoid some home construction, but she immediately became part of campus life. She would come to classes and entertain and calm the students, distract Zoom meetings by trying to climb out the window behind me, and helped catalogue all the squirrels on campus.
This year, the Ishaq lab said hello as well as good-bye to students, as we have been around long enough that students are matriculating (graduating) out and moving on to the next stage of their life. Emily Pierce (B.S. AVS 2021) is now attending veterinary school at Kansas State, and Jade Chin (B.S. AVS 2022) is attending Glasgow University for her senior year and veterinary school as part of their accelerated training program, while Grace Lee graduated from Bowdoin College (B.S. Neuroscience, 2021) and has been working there as a research assistant. Grace is a co-author with me on a paper currently in review, and other in preparation. Tindall defended her master’s of science thesis at Montana State University in August, and has been working as a research assistant performing more plant-soil feedback research while she finishes writing up the results from her graduate work for journal publication.
Publications

We had a productive year for peer-reviewed journal publications – with 8 accepted or published – the second highest total in a year I’ve ever had. Several of these have been in development since prior to 2021, several are the first publications for students, and all of which are thanks to my fabulous research collaboration team that now spans the globe. There are handful more papers in peer review at scientific journals, and others which are in preparation and which we hope to submit for peer review in 2022.
- Tindall’s first and first first-authored paper, on soil microbiomes:
- Ouverson, T., Eberly, J., Seipel, T., Menalled, F.D., Ishaq, S.L. 2021. Temporal soil bacterial community responses to cropping systems and crop identity in dryland agroecosystems of the Northern Great Plains. Frontiers in Sustainable Food Systems. Article. Invited submission to Plant Growth-Promoting Microorganisms for Sustainable Agricultural Production special collection.
- Olivia Choi‘s first first-authored paper (Kamath lab), on Salmonella in wild birds:
- Choi, O., Corl, A., Lublin, A., Ishaq, S.L., Charter, M., Pekarsky, S., Thie, N., Tsalyuk, M., Turmejan, S., Wolfenden, A., Bowie, R.C.K., Nathan, R., Getz, W.M., Kamath, P.L. 2021. High-throughput sequencing for examining Salmonella prevalence and pathogen – microbiota relationships in barn swallows. Frontiers in Ecology and Evolution 9:681.
- A paper featuring Adwoa Dankwa (Perry lab) and Usha Humagain (lab), which came about from my AVS 454/554 class:
- Dankwa, A.S., U. Humagain, S.L. Ishaq, C.J. Yeoman, S. Clark , D.C. Beitz, and E. D. Testroet. 2021. Determination of the microbial community in the rumen and fecal matter of lactating dairy cows fed on reduced-fat dried distillers grains with solubles. Animal 15(7):100281. Article.
- A paper featuring Alice Hotopp (Cammen Lab) and Sam Silverbrand (Kinnison lab), which came about from my AVS 454/554 class:
- Ishaq, S.L., A. Hotopp, S. Silverbrand, J.E. Dumont, A. Michaud, J. MacRae, S. P. Stock, E. Groden. 2021. Bacterial transfer from Pristionchus entomophagus nematodes to the invasive ant Myrmica rubra and the potential for colony mortality in coastal Maine. iScience 24(6):102663. Article.
- A paper to which I contributed:
- Zeng, H., Safratowich, B.D., Liu, Z., Bukowski, , M.R., Ishaq, S.L. 2021. Adequacy of calcium and vitamin D reduces inflammation, β-catenin signaling, and dysbiotic Parasutterella bacteria in the colon of C57BL/6 mice fed a Western-style diet. Journal of Nutritional Biochemistry 92: 108613. Article.
- The Microbes and Social Equity working group, described below, also had a debut publication
- Ishaq, S.L., Parada, F.J., Wolf, P.G., Bonilla, C.Y., Carney, M.A., Benezra, A., Wissel, E., Friedman, M., DeAngelis, K.M., Robinson, J.M., Fahimipour, A.K., Manus, M.B., Grieneisen, L., Dietz, L.G., Pathak, A., Chauhan, A., Kuthyar, S., Stewart, J.D., Dasari, M.R., Nonnamaker, E., Choudoir, M., Horve, P.F., Zimmerman, N.B., Kozik, A.J., Darling, K.W., Romero-Olivares, A.L., Hariharan, J., Farmer, N., Maki, K.A., Collier, J.L., O’Doherty, K., Letourneau, J., Kline, J., Moses, P.L., Morar, N. 2021. Introducing the Microbes and Social Equity Working Group: Considering the Microbial Components of Social, Environmental, and Health Justice. mSystems 6:4. Special Series: Social Equity as a Means of Resolving Disparities in Microbial Exposure
- Many MSE members also put together a review and perspective piece about setting research priorities:
- Robinson, J.M., Redvers, N., Camargo, A., Bosch, C.A., Breed, M.F., Brenner, L.A., Carney, M.A., Chauhan, A., Dasari, M., Dietz, L.G., Friedman, M., Grieneisen, L., Hoisington, A.J., Horve, P.F., Hunter, A., Jech, S., Jorgensen, A., Lowry, C.A., Man, I., Mhuireach, G., Navarro-Pérez, E., Ritchie, E.G., Stewart, J.D., Watkins, H., Weinstein, P., and Ishaq, S.L. 2021. Twenty important research questions in microbial exposure and social equity. mSystems Accepted Dec 2021. Special Series: Social Equity as a Means of Resolving Disparities in Microbial Exposure
- The first paper from a two year collaboration with Dr. Rabee, a researcher in Eqypt who is planning to visit my lab in 2022 as part of a fellowship he was awarded.
- Rabee, A.E., Sayed Alahl, A.A., Lamara, M., Ishaq, S.L. 2022. Fibrolytic rumen bacteria of camel and sheep and their applications in the bioconversion of barley straw to soluble sugars for biofuel production. PLoS ONE Accepted Dec 2021.
Presentations
The Ishaq lab and our collaborators gave virtual presentations this year to scientific audiences, as well as to grade k-12 students, to students and faculty as guest seminars, and as media/news interviews. I particularly enjoyed my chat on “Animal Microbiomes”, hosted by Sheba A-J on the WeTalkScience podcast. Students Emily Pierce, Myra Arshad, Johanna Holman, Joe Balkan, Louisa Colucci, Olivia Choi, Alice Hotopp, Sarah Hosler, and Grace Lee also gave or contributed to presentations in 2021.
- Ishaq, S. Introducing the Microbes and Social Equity Working Group: Considering the Microbial Components of Social, Environmental, and Health Justice. inVIVO Planetary Health. virtual. Dec 1 – 7, 2021. (invited)
- Holman* J., Ishaq S.L.., Li Y., Zhang T., Balkan J., Colucci L. Prevention of inflammatory bowel disease by broccoli-sourced and microbially-produced bioactives. Video presented at: OHS Student Led Research Panel, UC Davis; Nov 2021.
- Arshad*, M., Fludgate, P., Emera Rabee, A., Ishaq, S. “Preliminary results of camel rumen microbial make up”. Council on Undergraduate Research (CUR) Research Experiences for Undergraduates (REU) Symposium. (virtual). Oct 25, 2021.
- Choi*, O.N., Corl, A., Wolfenden, A., Lublin, A., Ishaq, S.L., Turjeman, S., Getz, W.M., Nathan, R., Bowie, R.C.K., Kamath, P.L. “High-throughput sequencing for examining Salmonella prevalence and pathogen -microbiota relationships in barn swallows.” 69th Annual – 14th Biennial Joint Conference of the Wildlife Disease Association & European Wildlife Disease Association (virtual) Aug 31 – Sept 2, 2021.
- The Microbes and Social Equity Working group, “Special Session 17: “Microbiomes and Social Equity” (19205).”, Ecological Society of America 2021. (virtual). Aug 5, 2021.36.
- Ishaq*, S.L., Lee, G., MacRae, J., Hamlin, H., Bouchard, D. “The effect of simulated warming ocean temperatures on the bacterial communities on the shells of healthy and epizootic shell diseased American Lobster (Homarus americanus).” Ecological Society of America 2021. (virtual). Aug 2-6, 2021. (accepted talk)
- Hotopp*, A., Silverbrand, S., Ishaq, S.L., Dumont, J., Michaud, A., MacRae, J., Stock, S.P., Groden, E. “Can a necromenic nematode serve as a biological Trojan horse for an invasive ant?” Ecological Society of America 2021. (virtual). Aug 2-6, 2021. (poster)
- Holman*, J., Ishaq, S.L., Li, Y., Zhang, T.. Prevention of Inflammatory Bowel Disease by Broccoli-sourced and Microbially-produced Bioactives. ASM Microbe/ISME World Microbe Forum 2021 (virtual). June 20-24, 2021. (poster)
- Ishaq*, S.L., Lee, G., MacRae, J., Hamlin, H., Bouchard, D. The Effect Of Simulated Warming Ocean Temperatures On The Bacterial Communities On The Shells Of Healthy And Epizootic Shell Diseased American Lobster (Homarus americanus). ASM Microbe/ISME World Microbe Forum 2021 (virtual). June 20-24, 2021. (poster)
- Pierce*, E., Hosler, S., Ishaq, S. Ideal Conditions for Cryptosporidium Attachment and Infection. UMaine Student Research Symposium (virtual). April 16, 2021. (poster)
Research
2021 has seen varied topics come through the lab, and there’s too much to include here, but I encourage you to check through the Blog page to find older research posts which provide updates.
I’ve been developing a number of aquaculture microbiome projects which are still trying to find funding, as well as continue the data analysis on a lobster shell microbiome dataset that is part of a larger project led by Dr. Deb Bouchard at the Aquaculture Research Institute (one of the researchers on the manuscripts in review and in preparation along with Grace Lee).
One pilot study did get funded, and a collaborative research team at UMaine (Drs. Erin Grey, Jen Perry, Tim Bowden) and the Downeast Institute (Dr. Brian Beal) got a few thousand dollars to collect about 200 samples to generate some data which will help us form a better idea of what’s going on. For that project, we are interested in a particular genus of bacteria, Vibrio, which contains many species that are found in the water or associated with marine animals. Some species of Vibrio can be pathogenic, and the team is curious about which species are present during scallop aquaculture productions, when they are present, and under which circumstances.
This summer and fall also saw a lot of activity on a collaborative project looking at small mammals in Maine and how climate change might be affecting the animals and the microbes they carry. This project has a whole team of undergraduate researchers working together from different labs (Drs. Danielle Levesque, Pauline Kamath, and Jason Johnston at UMPI), and we were poised to collect and measure dozens of animals and process lots of feces. Unfortunately, the mice and flying squirrels we were after outsmarted us and we caught fewer than 20 animals, which is enough for us to test our laboratory methods and streamline our workflow, but not enough from which to draw any conclusions. Even without a lot of data, we still consider the project to be successful because we trained so many students on various aspects of planning and conducting research, we gathered a lot of information from previous publications and are working on a literature review, and we have gained valuable perspective for planning a follow-up to this study.






We (Drs. Yanyan Li and Tao Zhang) are also continuing our collaborative investigations into the gut microbiome related to Inflammatory Bowel Disease using mouse models, looking at how dietary components can be used by gut microbes to produce anti-inflammatory compounds that can help the host reduce the symptoms of colitis. Last December and January we ran a mouse trial that generated hundreds of samples, and we have been processing them all year! Over the fall, our collaborators at the University of Vermont (Dr. Gary Mawe, Molly Hurd, Brigitte Lavoie) ran two more small mouse trials to test some exciting new things. We are hoping to publish the results from both studies in 2022.
Microbes and Social Equity
This was an exceptional year for the Microbes and Social Equity working group, which turned 2 years old in December, and is currently at 120 members plus several dozen newsletter subscribers! We grew so much that is was time to add Directors to the Leadership Team, to support our administration and communication needs.
In spring 2021, I organized a 14-speaker seminar series, which was attended by >300 people, and used for teaching materials at several colleges and universities. This led to a virtual symposium on “Microbes, Social Equity, and Rural Health”, June 14-18th, hosted by MSE and UMaine Medicine. This featured 15 speakers across 5 themed days with 3 plenary-style talks/day, followed by 90 min of small-group discussion led by speakers and MSE members. Participants were encouraged to “problem solve” a suggested topic or one of their own choosing to create action items that were meaningful to them, such as ideas for curricula development, identifying research needs or best practices, suggestions for engaging research in policy, and more. The symposium hosted 254 participants from 22 countries, students and researchers from various fields and career levels, Maine State legislators, and the public.
We have also been leading the development of a journal special collection in mSystems, the scope of which was developed in summer 2020 by select members of the MSE working group, and which has welcomed its first few contributions this year. The inaugural piece was one written by 35 MSE group members which introduced the group, established our mission statement, and outlined our goals.

We hosted a panel discussion at the 2021 Ecological Society for America meeting, and plan to host more conference sessions in 2022. In 2022, we will be hosting a spring seminar series, as well as a summer symposium which is still under development. We’ll be adding the rest of the contributions to the mSystems special collection, and hopefully some collaborative projects! There will also be a few presentations at scientific conferences.
Teaching
This was a busy year for teaching, as I had many more students this year than ever before. I’ve also had the chance to teach two of my four courses twice, which has allowed me to improve upon the course materials and how they are presented. There is too much to go into detail here, but I recommend checking out my previous posts on listening to your microbes (a creative assignment), responsible conduct of research (something I integrated into coursework), moving to suggested deadlines, choosing a graduate school, and how departments decide on their curricula.
Website and social media stats
The website gained a phenomenal amount of traffic this year, largely due to MSE, with more than 10,000 visitors and more than 25,000 views! I published more than 50 blog posts, as well as a few dozen more that were advertising events.

We had visitors from 125 countries around the globe!

Looking ahead to 2022
I’ll be starting 2022 early with proposal writing, drafting manuscripts, and teaching three classes (I offered to teach the third as overload because we are understaffed). I will be undergoing my third year review this spring, which is a milestone in my tenure-track journey. And, I already have a handful of presentations lined up:
- Ishaq, S. ”Microbes at the nexus of environmental, biological, and social research. 2nd Rhode Island Microbiome Symposium, in person, University of Rhode Island Kingston, RI, January 14, 2022. (invited plenary)
- Ishaq, S. et al. “TBD” Dartmouth Molecular Microbiology and Pathogenesis (M2P2), February 24-25, 2021.
- Ishaq, S. “Moose rumen microbes and you.” The Wildlife Society Nutritional Ecology Working Group Webinar, March 9, 2022.
- Ishaq S. Microbes and Social Equity: what is it and how do we do it? Part of Track Hub: ‘Field Work & DEI Part 1: Fostering Equitable Partnerships with the Communities in Your Field Work Location’. American Society for Microbiology (ASM) Microbe 2022, Washington, DC (USA), June 9-13, 2022. (invited)
- American Society for Microbiology (ASM) Microbe 2022 special session: “CTS16 (PPS) Cross-Track Symposium: Microbes and Social Equity: the Microbial Components of Social, Environmental, and Health Justice”. Washington, D.C. June 9-13, 2022. Organized by Ishaq, S.L. and featuring Drs. Ari Kozik, Carla Bonilla, and Monica Trujillo.